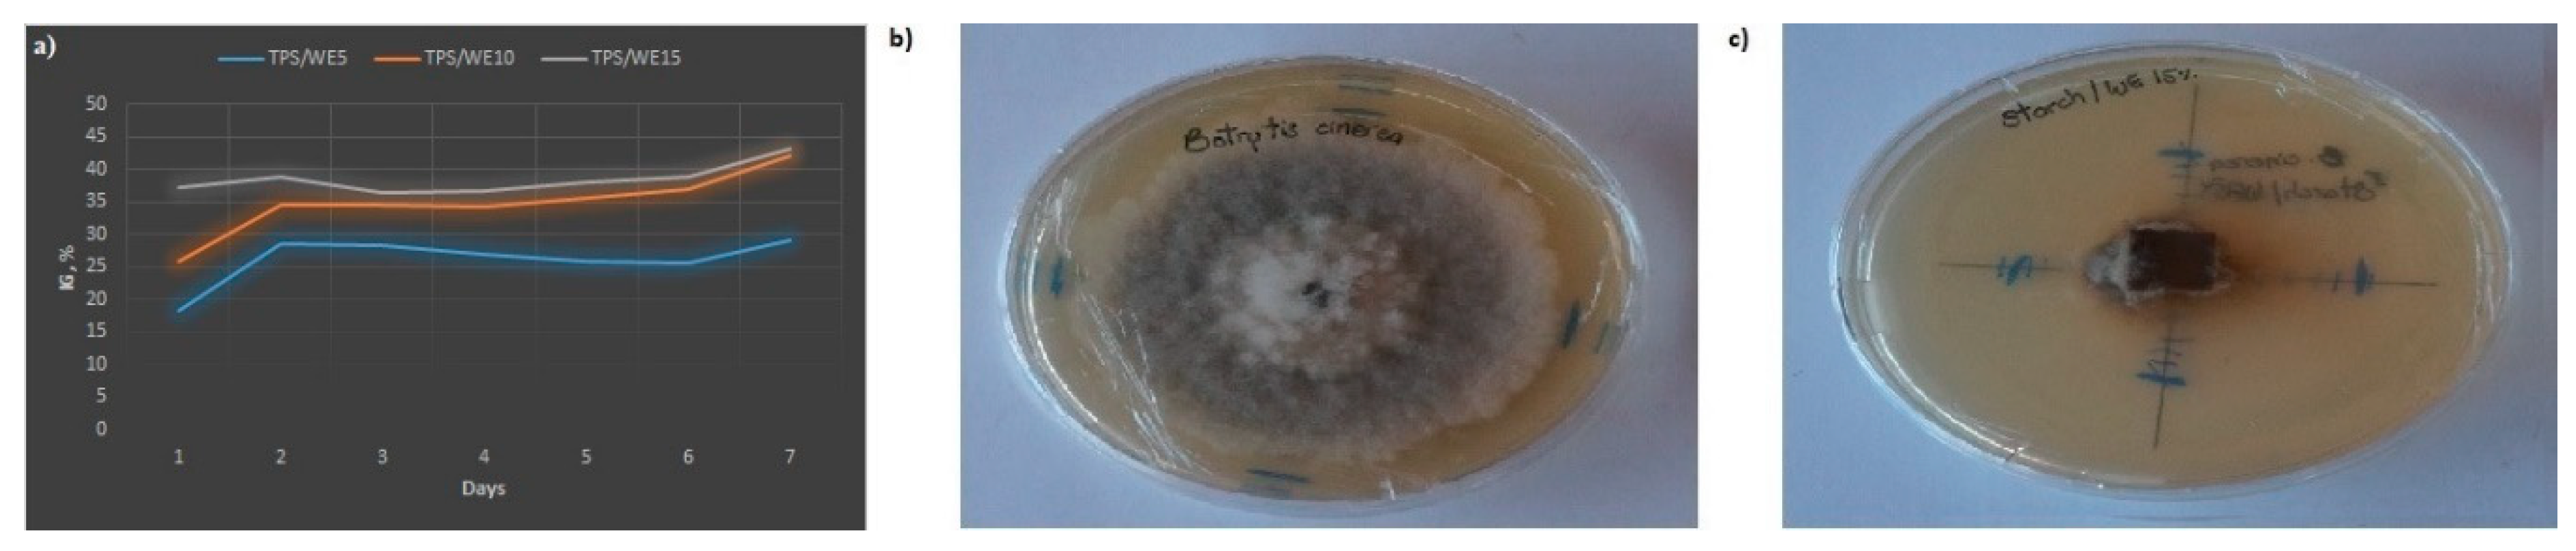
Molecules 25 01306 g006 Molecules 25 01306 g006

Physical-Chemical Evaluation of Active Food Packaging Material Based on Thermoplastic Starch Loaded with Grape cane Extract
Abstract
1. Introduction
2. Results and Discussion
2.1. FTIR Analysis
2.2. SEM Analysis
2.3. Mechanical Analysis
2.4. Thermal Analysis
2.5. Antioxidant Capacity
2.6. Microbiological Assay
3. Materials and Methods
3.1. Materials and Methods
3.2. Extraction Method from Grape cane Waste
3.3. Preparation of Starch-Material
3.4. Characterization of Materials
3.4.1. FTIR Analysis
3.4.2. SEM Analysis
3.4.3. Mechanical Analysis
3.4.4. Thermal Analysis
3.4.5. Antioxidant Capacity
3.4.6. In vitro Antimicrobial and Antifungal Activity
4. Conclusions
Author Contributions
Funding
Conflicts of Interest
References
- PlasticsEurope. Plastics-The facts 2017. Available online: https://www.plasticseurope.org/application/files/5715/1717/4180/Plastics_the_facts_2017_FINAL_for_website_one_page.pdf (accessed on 20 January 2020).
- Mexis, S.F.; Kontominas, M.G. PACKAGING | Active Food Packaging. In Encyclopedia of Food Microbiology; Batt, C., Tortorello Lou, M., Eds.; Elsevier: Ithaca, NY, USA, 2014; pp. 999–1005. [Google Scholar]
- Santagata, G.; Valerio, F.; Cimmino, A.; Dal Poggetto, G.; Masi, M.; Di Biase, M.; Malinconico, M.; Lavermicocca, P.; Evidente, A. Chemico-physical and antifungal properties of poly(butylene succinate)/cavoxin blend: Study of a novel bioactive polymeric based system. Eur. Polym. J. 2017, 94, 230–247. [Google Scholar] [CrossRef]
- Otoni, C.G.; Espitia, P.J.P.; Avena-Bustillos, R.J.; McHugh, T.H. Trends in antimicrobial food packaging systems: Emitting sachets and absorbent pads. Food Res. Int. 2016, 83, 60–73. [Google Scholar] [CrossRef]
- Garrido-Miranda, K.A.; Rivas, B.L.; Pérez -Rivera, M.A.; Sanfuentes, E.A.; Peña-Farfal, C. Antioxidant and antifungal effects of eugenol incorporated in bionanocomposites of poly(3-hydroxybutyrate)-thermoplastic starch. LWT 2018, 98, 260–267. [Google Scholar] [CrossRef]
- Campos-Requena, V.H.; Rivas, B.L.; Pérez, M.A.; Figueroa, C.R.; Figueroa, N.E.; Sanfuentes, E.A. Thermoplastic starch/clay nanocomposites loaded with essential oil constituents as packaging for strawberries − In vivo antimicrobial synergy over Botrytis cinerea. Postharvest Biol. Technol. 2017, 129, 29–36. [Google Scholar] [CrossRef]
- Castillo, L.A.; Farenzena, S.; Pintos, E.; Rodríguez, M.S.; Villar, M.A.; García, M.A.; López, O.V. Active films based on thermoplastic corn starch and chitosan oligomer for food packaging applications. Food Packag. Shelf Life 2017, 14, 128–136. [Google Scholar] [CrossRef]
- Mahieu, A.; Terrié, C.; Youssef, B. Thermoplastic starch films and thermoplastic starch/polycaprolactone blends with oxygen-scavenging properties: Influence of water content. Ind. Crops Prod. 2015, 72, 192–199. [Google Scholar] [CrossRef]
- Pola, C.C.; Medeiros, E.A.A.; Pereira, O.L.; Souza, V.G.L.; Otoni, C.G.; Camilloto, G.P.; Soares, N.F.F. Cellulose acetate active films incorporated with oregano ( Origanum vulgare ) essential oil and organophilic montmorillonite clay control the growth of phytopathogenic fungi. Food Packag. Shelf Life 2016, 9, 69–78. [Google Scholar] [CrossRef]
- Wang, H.J.; Jo, Y.H.; An, D.S.; Rhim, J.-W.; Lee, D.S. Properties of agar-based CO2 absorption film containing Na2CO3 as active compound. Food Packag. Shelf Life 2015, 4, 36–42. [Google Scholar] [CrossRef]
- Khan, B.; Bilal Khan Niazi, M.; Samin, G.; Jahan, Z. Thermoplastic Starch: A Possible Biodegradable Food Packaging Material-A Review. J. Food Process. Eng. 2017, 40, e12447. [Google Scholar] [CrossRef]
- Zhang, Y.; Rempel, C.; Liu, Q. Thermoplastic Starch Processing and Characteristics—A Review. Crit. Rev. Food Sci. Nutr. 2014, 54, 1353–1370. [Google Scholar] [CrossRef]
- Heydari, A.; Alemzadeh, I.; Vossoughi, M. Functional properties of biodegradable corn starch nanocomposites for food packaging applications. Mater. Des. 2013, 50, 954–961. [Google Scholar] [CrossRef]
- Feng, M.; Yu, L.; Zhu, P.; Zhou, X.; Liu, H.; Yang, Y.; Zhou, J.; Gao, C.; Bao, X.; Chen, P. Development and preparation of active starch films carrying tea polyphenol. Carbohydr. Polym. 2018, 196, 162–167. [Google Scholar] [CrossRef]
- Vaezi, K.; Asadpour, G.; Sharifi, H. Effect of ZnO nanoparticles on the mechanical, barrier and optical properties of thermoplastic cationic starch/montmorillonite biodegradable films. Int. J. Biol. Macromol. 2019, 124, 519–529. [Google Scholar] [CrossRef] [PubMed]
- Jumaidin, R.; Sapuan, S.M.; Jawaid, M.; Ishak, M.R.; Sahari, J. Effect of seaweed on mechanical, thermal, and biodegradation properties of thermoplastic sugar palm starch/agar composites. Int. J. Biol. Macromol. 2017, 99, 265–273. [Google Scholar] [CrossRef] [PubMed]
- Kargarzadeh, H.; Johar, N.; Ahmad, I. Starch biocomposite film reinforced by multiscale rice husk fiber. Compos. Sci. Technol. 2017, 151, 147–155. [Google Scholar] [CrossRef]
- Chang, P.R.; Jian, R.; Yu, J.; Ma, X. Fabrication and characterisation of chitosan nanoparticles/plasticised-starch composites. Food Chem. 2010, 120, 736–740. [Google Scholar] [CrossRef]
- Salaberria, A.M.; Diaz, R.H.; Labidi, J.; Fernandes, S.C.M. Role of chitin nanocrystals and nanofibers on physical, mechanical and functional properties in thermoplastic starch films. Food Hydrocoll. 2015, 46, 93–102. [Google Scholar] [CrossRef]
- Fabra, M.J.; López-Rubio, A.; Ambrosio-Martín, J.; Lagaron, J.M. Improving the barrier properties of thermoplastic corn starch-based films containing bacterial cellulose nanowhiskers by means of PHA electrospun coatings of interest in food packaging. Food Hydrocoll. 2016, 61, 261–268. [Google Scholar] [CrossRef]
- Ali, A.; Chen, Y.; Liu, H.; Yu, L.; Baloch, Z.; Khalid, S.; Zhu, J.; Chen, L. Starch-based antimicrobial films functionalized by pomegranate peel. Int. J. Biol. Macromol. 2019, 129, 1120–1126. [Google Scholar] [CrossRef]
- Oleyaei, S.A.; Almasi, H.; Ghanbarzadeh, B.; Moayedi, A.A. Synergistic reinforcing effect of TiO 2 and montmorillonite on potato starch nanocomposite films: Thermal, mechanical and barrier properties. Carbohydr. Polym. 2016, 152, 253–262. [Google Scholar] [CrossRef]
- Ghanbari, A.; Tabarsa, T.; Ashori, A.; Shakeri, A.; Mashkour, M. Preparation and characterization of thermoplastic starch and cellulose nanofibers as green nanocomposites: Extrusion processing. Int. J. Biol. Macromol. 2018, 112, 442–447. [Google Scholar] [CrossRef] [PubMed]
- Ostafińska, A.; Mikešová, J.; Krejčíková, S.; Nevoralová, M.; Šturcová, A.; Zhigunov, A.; Michálková, D.; Šlouf, M. Thermoplastic starch composites with TiO 2 particles: Preparation, morphology, rheology and mechanical properties. Int. J. Biol. Macromol. 2017, 101, 273–282. [Google Scholar] [CrossRef] [PubMed]
- Vergara, C.; von Baer, D.; Mardones, C.; Wilkens, A.; Wernekinck, K.; Damm, A.; Macke, S.; Gorena, T.; Winterhalter, P. Stilbene Levels in Grape cane of Different Cultivars in Southern Chile: Determination by HPLC-DAD-MS/MS Method. J. Agric. Food Chem. 2012, 60, 929–933. [Google Scholar] [CrossRef]
- Sáez, V.; Pastene, E.; Vergara, C.; Mardones, C.; Hermosín-Gutiérrez, I.; Gómez-Alonso, S.; Gómez, M.V.; Theoduloz, C.; Riquelme, S.; von Baer, D. Oligostilbenoids in Vitis vinifera L. Pinot Noir grape cane extract: Isolation, characterization, in vitro antioxidant capacity and anti-proliferative effect on cancer cells. Food Chem. 2018, 265, 101–110. [Google Scholar] [CrossRef]
- Gorena, T.; Mardones, C.; Vergara, C.; Saez, V.; von Baer, D. Evaluation of the Potential of Grape canes as a Source of Bioactive Stilbenoids. In Advances in Wine Research; Ebeler, S.B., Sacks, G., Vidal, S., Winterhalter, P., Eds.; ACS Symposium series; Oxford University Press: Oxford, UK, 2015; pp. 347–363. [Google Scholar]
- Schnee, S.; Queiroz, E.F.; Voinesco, F.; Marcourt, L.; Dubuis, P.-H.; Wolfender, J.-L.; Gindro, K. Vitis vinifera Canes, a New Source of Antifungal Compounds against Plasmopara viticola, Erysiphe necator, and Botrytis cinerea. J. Agric. Food Chem. 2013, 61, 5459–5467. [Google Scholar] [CrossRef] [PubMed]
- Corrales, M.; Han, J.H.; Tauscher, B. Antimicrobial properties of grape seed extracts and their effectiveness after incorporation into pea starch films. Int. J. Food Sci. Technol. 2009, 44, 425–433. [Google Scholar] [CrossRef]
- Xu, Y.; Scales, A.; Jordan, K.; Kim, C.; Sismour, E. Starch nanocomposite films incorporating grape pomace extract and cellulose nanocrystal. J. Appl. Polym. Sci. 2017, 134, 44438. [Google Scholar] [CrossRef]
- Gutiérrez, T.J.; Herniou-Julien, C.; Álvarez, K.; Alvarez, V.A. Structural properties and in vitro digestibility of edible and pH-sensitive films made from guinea arrowroot starch and wastes from wine manufacture. Carbohydr. Polym. 2018, 184, 135–143. [Google Scholar] [CrossRef]
- Castillo, L.A.; López, O.V.; García, M.A.; Barbosa, S.E.; Villar, M.A. Crystalline morphology of thermoplastic starch/talc nanocomposites induced by thermal processing. Heliyon 2019, 5, e01877. [Google Scholar] [CrossRef]
- Musa, M.; Yoo, M.; Kang, T.; Kolawole, E.; Ishiaku, U.; Yakubu, M.; Whang, D. Characterization and Thermomechanical Properties of Thermoplastic Potato Starch. Res. Rev. J. Eng. Technol. 2013, 2, 9–16. [Google Scholar]
- Agustin-Salazar, S.; Gamez-Meza, N.; Medina-Juàrez, L.À.; Soto-Valdez, H.; Cerruti, P. From Nutraceutics to Materials: Effect of Resveratrol on the Stability of Polylactide. ACS Sustain. Chem. Eng. 2014, 2, 1534–1542. [Google Scholar] [CrossRef]
- Billes, F.; Mohammed-Ziegler, I.; Mikosch, H.; Tyihák, E. Vibrational spectroscopy of resveratrol. Spectrochim. Acta Part. A Mol. Biomol. Spectrosc. 2007, 68, 669–679. [Google Scholar] [CrossRef]
- Zhu, F. Interactions between starch and phenolic compound. Trends Food Sci. Technol. 2015, 43, 129–143. [Google Scholar] [CrossRef]
- Davoodi, M.; Kavoosi, G.; Shakeri, R. Preparation and characterization of potato starch-thymol dispersion and film as potential antioxidant and antibacterial materials. Int. J. Biol. Macromol. 2017, 104, 173–179. [Google Scholar] [CrossRef] [PubMed]
- Nogueira, G.F.; Soares, C.T.; Cavasini, R.; Fakhouri, F.M.; de Oliveira, R.A. Bioactive films of arrowroot starch and blackberry pulp: Physical, mechanical and barrier properties and stability to pH and sterilization. Food Chem. 2019, 275, 417–425. [Google Scholar] [CrossRef] [PubMed]
- Homayouni, H.; Kavoosi, G.; Nassiri, S.M. Physicochemical, antioxidant and antibacterial properties of dispersion made from tapioca and gelatinized tapioca starch incorporated with carvacrol. LWT 2017, 77, 503–509. [Google Scholar] [CrossRef]
- Silva, Â.; Duarte, A.; Sousa, S.; Ramos, A.; Domingues, F.C. Characterization and antimicrobial activity of cellulose derivatives films incorporated with a resveratrol inclusion complex. LWT 2016, 73, 481–489. [Google Scholar] [CrossRef]
- da Silva, R.D.; Teixeira, J.A.; Nunes, W.D.G.; Zangaro, G.A.C.; Pivatto, M.; Caires, F.J.; Ionashiro, M. Resveratrol: A thermoanalytical study. Food Chem. 2017, 237, 561–565. [Google Scholar] [CrossRef]
- Öğünç, Y.; Demirel, M.; Yakar, A.; İncesu, Z. Vincristine and ε-viniferine-loaded PLGA-b-PEG nanoparticles: Pharmaceutical characteristics, cellular uptake and cytotoxicity. J. Microencapsul. 2017, 34, 38–46. [Google Scholar] [CrossRef]
- Ortiz-Vazquez, H.; Shin, J.; Soto-Valdez, H.; Auras, R. Release of butylated hydroxytoluene (BHT) from Poly(lactic acid) films. Polym. Test. 2011, 30, 463–471. [Google Scholar] [CrossRef]
- Sun, X.; Peng, B.; Yan, W. Measurement and correlation of solubility of trans-resveratrol in 11 solvents at T= (278.2, 288.2, 298.2, 308.2, and 318.2) K. J. Chem. Thermodyn. 2008, 40, 735–738. [Google Scholar] [CrossRef]
- Ju, Y.; Zhang, A.; Fang, Y.; Liu, M.; Zhao, X.; Wang, H.; Zhang, Z. Phenolic compounds and antioxidant activities of grape canes extracts from vineyards. Spanish, J. Agric. Res. 2016, 14, e0805. [Google Scholar] [CrossRef]
- Zhang, A.; Fang, Y.; Wang, H.; Li, H.; Zhang, Z. Free-Radical Scavenging Properties and Reducing Power of Grape cane Extracts from 11 Selected Grape Cultivars Widely Grown in China. Molecules 2011, 16, 10104–10122. [Google Scholar] [CrossRef]
- Li, X.; Xie, Y.; Xie, H.; Yang, J.; Chen, D. π-π Conjugation Enhances Oligostilbene’s Antioxidant Capacity: Evidence from α-Viniferin and Caraphenol, A. Molecules 2018, 23, 694. [Google Scholar] [CrossRef] [PubMed]
- Jin, Q.; Han, X.H.; Hong, S.S.; Lee, C.; Choe, S.; Lee, D.; Kim, Y.; Hong, J.T.; Lee, M.K.; Hwang, B.Y. Antioxidative oligostilbenes from Caragana sinica. Bioorg. Med. Chem. Lett. 2012, 22, 973–976. [Google Scholar] [CrossRef] [PubMed]
- Wang, Y.; Zhang, R.; Ahmed, S.; Qin, W.; Liu, Y. Preparation and Characterization of Corn Starch Bio-Active Edible Packaging Films Based on Zein Incorporated with Orange-Peel Oil. Antioxidants 2019, 8, 391. [Google Scholar] [CrossRef]
- Yun, D.; Cai, H.; Liu, Y.; Xiao, L.; Song, J.; Liu, J. Development of active and intelligent films based on cassava starch and Chinese bayberry ( Myrica rubra Sieb. et Zucc.) anthocyanins. RSC Adv. 2019, 9, 30905–30916. [Google Scholar] [CrossRef]
- Piñeros-Hernandez, D.; Medina-Jaramillo, C.; López-Córdoba, A.; Goyanes, S. Edible cassava starch films carrying rosemary antioxidant extracts for potential use as active food packaging. Food Hydrocoll. 2017, 63, 488–495. [Google Scholar] [CrossRef]
- Langcake, P.; Pryce, R.J. The production of resveratrol by Vitis vinifera and other members of the Vitaceae as a response to infection or injury. Physiol. Plant. Pathol. 1976, 9, 77–86. [Google Scholar] [CrossRef]
- Adrian, M.; Jeandet, P. Effects of resveratrol on the ultrastructure of Botrytis cinerea conidia and biological significance in plant/pathogen interactions. Fitoterapia 2012, 83, 1345–1350. [Google Scholar] [CrossRef]
- Pastor, C.; Sánchez-González, L.; Chiralt, A.; Cháfer, M.; González-Martínez, C. Physical and antioxidant properties of chitosan and methylcellulose based films containing resveratrol. Food Hydrocoll. 2013, 30, 272–280. [Google Scholar] [CrossRef]
- Lozano-Navarro, J.; Díaz-Zavala, N.; Velasco-Santos, C.; Martínez-Hernández, A.; Tijerina-Ramos, B.; García-Hernández, M.; Rivera-Armenta, J.; Páramo-García, U.; Reyes-de la Torre, A. Antimicrobial, Optical and Mechanical Properties of Chitosan–Starch Films with Natural Extracts. Int. J. Mol. Sci. 2017, 18, 997. [Google Scholar] [CrossRef]
- Li, X.-Z.; Wei, X.; Zhang, C.-J.; Jin, X.-L.; Tang, J.-J.; Fan, G.-J.; Zhou, B. Hypohalous acid-mediated halogenation of resveratrol and its role in antioxidant and antimicrobial activities. Food Chem. 2012, 135, 1239–1244. [Google Scholar] [CrossRef] [PubMed]
- Paulo, L.; Ferreira, S.; Gallardo, E.; Queiroz, J.A.; Domingues, F. Antimicrobial activity and effects of resveratrol on human pathogenic bacteria. World, J. Microbiol. Biotechnol. 2010, 26, 1533–1538. [Google Scholar] [CrossRef]
- Mardones, C.; Von Baer, D.; Vergara, C.; Fuentealba, C.; Escobar, D.; Riquelme, S. Un procedimiento para aumentar el contenido de estilbenos, esencialmente resveratrol, en sarmientos provenientes de las podas de Vitis vinífera. Chilean Patent 54541, 2014. [Google Scholar]
- Ventura-Aguilar, R.I.; Bautista-Baños, S.; Flores-García, G.; Zavaleta-Avejar, L. Impact of chitosan based edible coatings functionalized with natural compounds on Colletotrichum fragariae development and the quality of strawberries. Food Chem. 2018, 262, 142–149. [Google Scholar] [CrossRef] [PubMed]
Sample Availability: Samples of the compounds are available from the authors. |

| Sample | WL100,% | WL180,% | Tonset, °C | Tdeg, °C | Char Residue, °C |
|---|---|---|---|---|---|
| TPS | 2 | 8 | 280 | 312 | 10 |
| WE | 3 | 14 | 220 | 240–390 | 36 |
| TPS/WE5 | 2 | 9 | 273 | 312 | 14 |
| TPS/WE10 | 2 | 9 | 271 | 314 | 17 |
| TPS/WE15 | 2 | 9 | 269 | 319 | 19 |
© 2020 by the authors. Licensee MDPI, Basel, Switzerland. This article is an open access article distributed under the terms and conditions of the Creative Commons Attribution (CC BY) license (http://creativecommons.org/licenses/by/4.0/).
Share and Cite
Díaz-Galindo, E.P.; Nesic, A.; Cabrera-Barjas, G.; Mardones, C.; von Baer, D.; Bautista-Baños, S.; Dublan Garcia, O. Physical-Chemical Evaluation of Active Food Packaging Material Based on Thermoplastic Starch Loaded with Grape cane Extract. Molecules 2020, 25, 1306. https://doi.org/10.3390/molecules25061306
Díaz-Galindo EP, Nesic A, Cabrera-Barjas G, Mardones C, von Baer D, Bautista-Baños S, Dublan Garcia O. Physical-Chemical Evaluation of Active Food Packaging Material Based on Thermoplastic Starch Loaded with Grape cane Extract. Molecules. 2020; 25(6):1306. https://doi.org/10.3390/molecules25061306
Chicago/Turabian StyleDíaz-Galindo, Edaena Pamela, Aleksandra Nesic, Gustavo Cabrera-Barjas, Claudia Mardones, Dietrich von Baer, Silvia Bautista-Baños, and Octavio Dublan Garcia. 2020. "Physical-Chemical Evaluation of Active Food Packaging Material Based on Thermoplastic Starch Loaded with Grape cane Extract" Molecules 25, no. 6: 1306. https://doi.org/10.3390/molecules25061306
APA StyleDíaz-Galindo, E. P., Nesic, A., Cabrera-Barjas, G., Mardones, C., von Baer, D., Bautista-Baños, S., & Dublan Garcia, O. (2020). Physical-Chemical Evaluation of Active Food Packaging Material Based on Thermoplastic Starch Loaded with Grape cane Extract. Molecules, 25(6), 1306. https://doi.org/10.3390/molecules25061306










